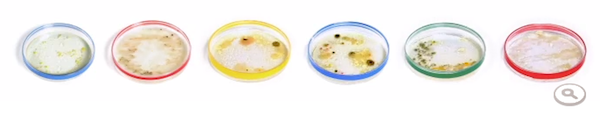
google-petri-doodle

Julius Richard Petri, inventor of the Petri dish, was born on this date 161 years ago, and Google has marked the occasion with a Google Doodle.
The logo features six Petri dishes in the Google colors, and when you click for the animation, you see a hand swapping each dish, and then watch as the bacteria grows in each one.
Then, once the bacteria has finished growing, you can mouseover to see what was cultured in each Petri dish, which includes smelly socks, a doorknob, a keyboard, a dog’s mouth, soil in a rainstorm, and a kitchen dish sponge.
Petri invented the dishes in 1877 while assigned to the Imperial Health Office in Germany as an assistant to Robert Koch, who is referred to as the father of modern bacteriology.
Leave a Reply
You must be logged in to post a comment.